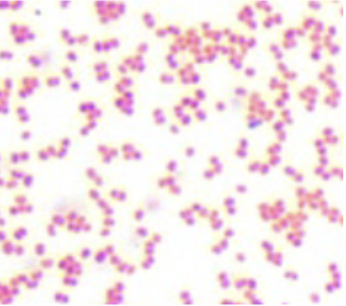
<p>Gram and morphology of this bacteria: pink to red stained bacteria with a spherical to bean shaped morphology</p>

1/89
Looks like no tags are added yet.
Name | Mastery | Learn | Test | Matching | Spaced | Call with Kai |
|---|
No analytics yet
Send a link to your students to track their progress
Microorganisms not known to cause disease in healthy adults. SMP’s here are the basic “hygiene” practices that apply to all labs that manipulate microorganisms. PPE is not required.
BSL 1
Indigenous microorganisms that can lead to diseases of varying severity in healthy adults. PPE must be worn including lab coats and gloves. Eye protection and face shields are worn when needed. Work that may generate aerosols or splashes are performed in a biological safety cabinet/hood.
BSL 2
Indigenous or exotic microorganisms that cause serious or potentially lethal disease through respiratory transmission. Locking, double door access separates the lab’s work area from other parts of the facility. PPE must be worn including lab coats, gloves, eye protection, and respirators. Decontamination of all waste and lab clothing before laundering. Laboratory must have negative airflow (air can not escape to surrounding rooms) and exhaust air cannot be recirculated (must be vented to outside of building after decontamination by ultra-filtration).
BSL 3
Microorganisms that are dangerous and exotic with high risk of aerosol transmitted infections. Rarely are there treatments or vaccines for these microorganisms, and the diseases they cause are frequently fatal. The laboratory must be in a separate building or in an isolated and restricted zone of the building. All work with microorganisms must be performed in a Class III biosafety cabinet or by wearing a full body, positive pressure suit. Decontaminate all materials before exiting lab (including clothes). Shower upon exiting lab. Change clothes before exiting lab.
BSL 4
The concept that microorganisms are everywhere.
Ubiquity of Microorganisms
The undesired introduction of impurities like microbes, into or onto an item
Contamination
When only one type of microbe is grown on an agar plate or in liquid broth culture.
Pure culture
What country was the first microscope invented in?
Holland
Simplest form of microscopy where light is either passed through, or reflected off, a specimen. Illumination is not altered by devices that change the properties of light (such as polarizers or filters). Requires the use of stains to visualize cells.
Brightfield Microscope
Converts the differences in optical density (refractive index) of cells into different shades of brightness (contrast). Allows for the visualization of morphology, external structures, and some internal structures. Stains are not required.
Phase contrast microscopes
Contrast is created by a bright specimen on a dark background. It is ideal for revealing morphology and external structures, but not internal structures. Stains are not required.
Darkfield microscopes
Uses high intensity illumination to excite fluorescent molecules (fluorophores) in the sample. When a molecule absorbs photons, electrons are excited to a higher energy level. As electrons 'relax' back to the ground-state, vibrational energy is lost and, as a result, the emission spectrum is shifted to longer wavelengths; colored light emanates from the sample (and not the illuminating light).
Fluorescent microscopes
The ability of a microscope to remain relatively in focus when changing from lower power objective to a higher power objective.
Parfocal
A mathematical expression that describes how the condenser lens concentrates and focuses the light rays from the light source.
Numerical aperture
The ability of a lens system to show two closely spaced objects as distinct and separate.
Resolving power
The distance between the bottom of the objective lens and the slide.
Working distance

What is 1?
Ocular

What is 2?
Binocuar Head

What is 3?
Objective

What is 4?
Turret

What is 5?
Stage

What is 6?
Condenser

What is 7?
Stage Adjustment Knobs

What is 8?
Fine Focus Knob

What is 9?
Coarse Focus Knob

What is 10?
Voltage Control Dial

What is 11?
Diaphram
The crystal violet and safranin needed in Gram Staining are types of ___ stain.
differential
Why do we need to stain bacteria to be see in brightfield microscopy?
Bacteria are 80% water

Gram and morphology of this bacteria: purple stained bacteria with a spherical morphology
Gram Positive Cocci
Gram and morphology of this bacteria: pink to red stained bacteria with a spherical to bean shaped morphology
Gram negative cocci

Gram and morphology of this bacteria: purple stained bacteria with a rod-shaped morphology.
Gram positive rods (bacilli)

Gram and morphology of this bacteria: pink to red stained bacteria with a rod-shaped morphology
Gram negative straight rods (bacilli)

Gram and morphology of this bacteria: pink to red stained bacteria with a rod-shaped morphology but are also curved or spiral
Gram negative curved/spiral rods (bacilli)
List the gram staining steps in order:
2.Ethanol rinse followed by water rinse
5.Heat fix to slide
4.Safranin
3.Crystal Violet
1.Iodine fix
5, 3, 1, 2, 4
Bacteria that require oxygen for growth and rely exclusively on aerobic respiration for energy production, as they cannot survive or grow without O₂.
Strict (obligate) aerobes
Bacteria that grow optimally with oxygen using aerobic respiration but can switch to fermentation or anaerobic respiration (using alternative electron acceptors) in its absence, allowing growth with or without O₂.
Facultative anaerobes
Bacteria that do not use oxygen for respiration and rely solely on fermentation for energy, but they can tolerate its presence and grow in environments with or without O₂.
Aerotolerant anaerobes
Bacteria that cannot tolerate oxygen, as it is toxic to them, and they grow only in oxygen-free environments using fermentation or anaerobic respiration.
Strict (obligate) anaerobes
Enzyme that catalyzes the decomposition of H₂O₂ into harmless water and oxygen
Catalase
A potent oxidizing agent that can harm cellular components such as enzymes, DNA, RNA, and lipids by causing oxidative damage; H2O2
Hydrogen Peroxide
Converts superoxide radicals (O₂-) into H₂O₂ and O₂, further aiding oxygen tolerance
Superoxide dismutase (SOD),
Differentiates microorganisms based on their ability to produce the catalase enzyme. Catalase breaks hydrogen peroxide down to water and oxygen. Positive: Bubbles. Negative: No bubbles
Catalase
Results from the Gram stain can be verified by performing this test. Gram negative cells have a thin peptidoglycan layer in their cell wall and will lyse in 3% solution, releasing their DNA and causing the liquid to become very viscous. Often, "strings" of DNA can be seen adhering to the loop as it is raised from the slide.
KOH (potassium hydroxide) test
Contains substances that cause some bacteria to take on an appearance that distinguishes them from other bacteria
Differential medium
Media that will allow only certain groups of microorganisms to grow and will inhibit
the growth of other microorganisms
Selective medium
Distinguishes when a bacteria can ferment mannitol, producing acid and changing a pH indicator in the media from red to yellow around the colonies, or cannot ferment mannitol, and their growth on this plate results in the agar remaining red around the colonies.
Mannitol Salt Agar (MSA)
Differential medium to show which organisms produce exotoxins (poisons) that completely lyse (destroy) red blood cells in blood agars. TSA w/ 5% sheep blood cells
Sheep blood agar (SBA)
Complete lysis of red blood cells around a colony is known as ___
Beta hemolysis
Partially breakdown red blood cells producing a greenish discoloration around the colonies known as ___
Alpha hemolysis
No effect on the red blood cells in a blood agar plate/ no exhibit of any hemolysis of blood is called ___
Gamma hemolysis
Differentiates microorganisms based on their ability to grow in 6.5% NaCl. Positive: Growth (turbidity). Negative: No growth (clear)
BHI with 6.5% NaCl
Differentiates microorganisms based on their ability to hydrolyze esculin to esculetin and dextrose. The esculetin reacts with ferric citrate in the medium to form a dark brown-black complex. Positive: Blackening of the tube. Negative: No color change or less than 1⁄2 of the slant is black
Bile Esculin Hydrolysis
Detection of coagulase that is excreted by Staphylococcus aureus that causes fibrin clot formation. Positive: Coagulation of the plasma (clot formation). Negative: No coagulation/clot formation
Coagulase
Differentiates microorganisms based on their hemolytic activity on sheep blood agar (TSA w/ 5% sheep blood cells). Gamma or non-hemolytic - no hemolysis or discoloration of the media. Alpha - incomplete hemolysis or greening of the media. Beta - complete hemolysis or clearing of the media.
Hemolysis on SBA (Sheep Blood Agar)
Differentiates microorganisms based on their ability to reduce nitrate to nitrite or ammonia or nitrogenous gas. Incomplete Positive: Red coloration after the addition Nitrate A and B reagents. Complete Positive: No color change after the addition Nitrate A & B reagents & the addition of zinc. Negative: Red coloration after the addition of zinc.
Nitrate Reduction
Differentiates organisms based on carbohydrate fermentation. This media contains specific carbohydrates and the pH indicator phenol red. When an organism is able to ferment the carbohydrate present, an acid or an acid and gas are produced and the indicator changes from red to yellow. If the carbohydrate is not fermented, the color will remain red. Positive: Yellow color (fermentation) Negative: Red color
Phenol Red Carbohydrate Tubes (Arabinose, Lactose, Trehalose, Mannitol, Sucrose, Xylose, etc.)
Differentiates microorganisms based on their ability to hydrolyze starch. Positive: Dark agar with tan/brown clearing around streak line. Negative: Dark agar up to the streak line
Starch Hydrolysis
Optimal growth between -5°C and 20°C. These bacteria can be found in the icy waters of the Arctic and the Antarctic.
Psycrophiles
Optimal growth between 20°C and 50°C. Most bacteria fall into this category. For example, most pathogens grow between 35°C and 40°C.
Mesophiles
Optimal growth between 50°C and 80°C. Bacteria in this category occur in soils where the midday temperature can reach greater than 50°C or in compost piles where temperatures exceed 60-65°C.
Thermophiles
Optimal growth is above 80°C. These organisms have been isolated from thermal vents deep within the ocean floor and from volcanic heated hot springs.
Hyperthermophiles
Pathogens, can also grow at 4°C.
Psychrotrophs
Rich liquid medium that supports the growth of both aerobic and anaerobic bacteria. Also contains a dye called resaruzin that turns pink in the presence of oxygen.
FTM (Fluid Thioglycollate Medium)
Substances such as alcohol or betadine that inhibit microbial growth or kill microorganisms and are gentle enough to be applied to living tissue.
Antiseptics
Chemical agents that are applied to inanimate objects such as floors, walls, and tabletops to kill microorganisms
Disinfectants
Agents that reduce microbial numbers to a safe level but do not completely eliminate all microbes
Sanitizers
A particular agent only inhibits the growth of bacterial cells but does not kill them
Bacteriostatic
Agents that kill bacterial cells
Bactericidal
Differentiates microorganisms based on their ability to produce a neutral end product, 2,3 butanediol from glucose fermentation. This end product is oxidized to form acetoin that is detected with the addition of the reagents A & B (alpha-naphthol and KOH). Positive: Red color development within 30 minutes. Negative: No color change or a yellow to brown color should be considered negative
Voges-Proskauer (VP)
Differentiates microorganisms based on urease production. The enzyme urease will hydrolyze urea yielding ammonia. Ammonia is alkaline and in the presence of the pH indicator phenol red, will change the color of the media from light orange to an intense pink-red color. Positive: Intense pink-red color. Negative: No color change
Urea
Differentiates microorganisms based on hydrogen sulfide production, indole production, and motility. H2S Production: Positive: Blackening along the stab line or throughout the tube. Negative: No color change. Indole Production: Positive: Red color at top of agar. Negative: No color change. Motility: Positive: Diffuse growth outward from the stab line (appears turbid) Negative: Growth only along the stab line.
SIM: H2S Production, Indole Production, and Motility
Differentiate microorganisms based on the ability to produce phenylalanine deaminase. This enzyme removes the amine group from the aminoacid phenylalanine and releases the amine group as free ammonia. As a result of this reaction, phenylpyruvic acid is also produced. If phenylpyruvic acid was produced, it will react with ferric chloride and turn dark green. Positive: Green coloration. Negative: Yellow coloration
Phenylalanine
Differentiates microorganisms based on oxidative or fermentative metabolism of carbohydrate in tube. Positive: (O) Oxidative Reaction: Yellow color in the open tube only (no oil). Positive: (F) Fermentative Reaction: Yellow color in both open tube & closed tube (oil added). Negative: Neither oxidative nor fermentative reaction: Green color remains in either the O or the F tube.
O/F Glucose (Oxidation/Fermentation Reaction)
Differentiates microorganisms based on their ability to produce and maintain stable acid end products from glucose fermentation. Positive: Red color (immediate). Negative: Yellow color / no color
Methyl Red (MR)
Selects microorganisms based on their ability to grow in presence of eosin Y and methylene blue. Differentiates microorganisms by their ability to vigorously ferment lactose and produce acid. Positive: Growth (+) / Acid (++) → Vigorous lactose fermenter with excessive acid formation; Metallic green sheen/purple colonies (primarily, but not always E. coli). Positive: Growth (+) / Acid (+)→ Moderate to slow lactose fermenter with moderate acid formation; Purple colonies. Negative: Growth (+) / Acid (-)→ No lactose fermentation or no growth; Pink or clear/grey colorless colonies
EMB (Eosin Methylene Blue Agar)
Differentiates microorganisms based on their ability to utilize citrate as a sole carbon source and ammonium salts as a sole nitrogen source. Organisms that are able to utilize citrate and ammonium salts will grow on this media producing ammonia. The ammonia is alkaline causing the bromothymol blue pH indicator to shift from green to blue. Positive: Growth with an intense blue color. Negative: No growth / no color change (remains green)
Citrate
The organism is Gram positive, Cocci, Catalase negative, but can’t grow at 45° C, it belongs to the family
Streptococcaceae
The organism is Gram positive, Cocci, Catalase negative, but can grow at 45° C, it belongs to the family
Enterococcus
Organism is Gram positive, Cocci, Catalase positive, but Oxidase negative so it belongs to family:
Staphylococcaceae
Organism is Gram positive, Cocci, Catalase positive, but Oxidase positive so it belongs to family:
Micrococcacae
Organism is Gram positive, Rod, so it belongs to family:
Bacillaceae
Organism is Gram negative, Rod, Oxidase positive, it belongs to family:
Pseudomonadaceae
Organism is Gram negative, Rod, Oxidase negative, it belongs to family:
Enterobacteriaceae
Differentiates microorganisms based on their ability to spread across a plate demonstrating swarming motility. Positive: Growth radiating from the streak lines usually covering the entire surface of the plate. Negative: Limited or no growth radiating from the streak lines. Isolated colonies only.
Swarming motility
Differentiates microorganisms by their ability to produce a red pigment (prodigiosin) when incubated at 25°C.
Production of Red Pigment at 25°C
Differentiate microorganisms based on the ability to produce phenylalanine deaminase. The enzyme removes the amine group from the amino acid phenylalanine and releases the amine group as free ammonia. As a result of this reaction, phenylpyruvic acid is also produced. The phenylpyruvic acid reacts with ferric chloride and turns dark green. Positive: Green. Negative: Yellow
Phenylalanine
Differentiates microorganisms based on susceptibility to bacitracin. Susceptible: Any size zone of inhibition around the disk (hold plate up to light to see zone of inhibition). Resistant: No zone of inhibition (growth up to the edge of the disk)
Bacitracin disk
Zone of inhibition and resistance for Novobiocin
≥ 17mm; ≤16 mm
Zone of inhibition and resistance for Optochin (P) disk
> 14mm; <14mm